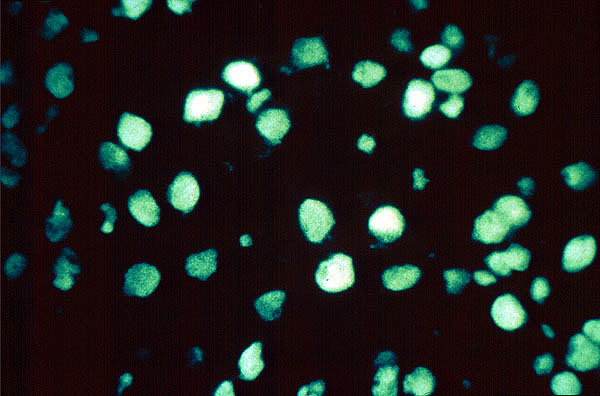

Antinuclear antibody, Lupus erythematosus
Click picture to enlarge. Close window to return
The anti-nuclear antibody test is often used to diagnose lupus erythmatosis. The patient's serum is incubated with a unicellular organism (Crithidia). Auto-antibodies to nuclear proteins will give rise to green fluorescence, following incubation with a second, fluorocein-labeled anti-human antibody (Copyright 1996, University of Utah)